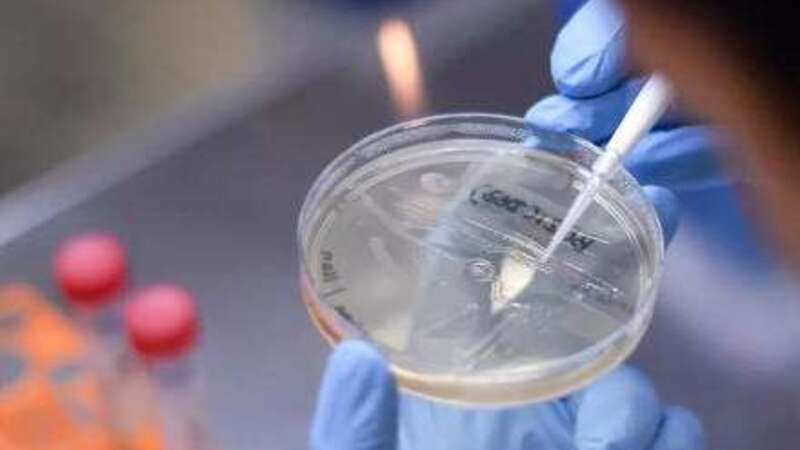

Frygt for Delta-varianten i Spanien
Skrevet af Torben Wilkenschildt, man, 21/06/2021 - 10:57
Coronavirus Turisme Sundhed & sygdom | AMIGOS
CORONA: Eksperter forventer, at Delta-varianten vil være den dominerende i Spanien om en måned.
Alt tyder i øjeblikket så lyst med åbninger og på det nærmeste frie rejser i hele EU. Men den indiske corona variant Delta truer glæden lidt.
Kan måske også interessere dig
Historisk sundhedsforbedring i Spanien
Markant fald i dødeligheden, især blandt ældre borgere.
Sådan ser partibosserne på valgresultatet i Aragón
For Sánchez betyder nederlaget, at han skal gentænke sin strategi, hvis han vil undgå en lignende nedsmeltning på nationalt plan.
10 rigtigt go’e grunde til at besøge Spaniens smukke hovedstad i efteråret
Madrid er fyldt med alt, hvad hjertet kan begære - og lidt til!
Kommentarer
COPYRIGHT: Det er ikke tilladt at kopiere hverken helt eller delvist fra Spanien i dag uden aftale.









.jpg)











